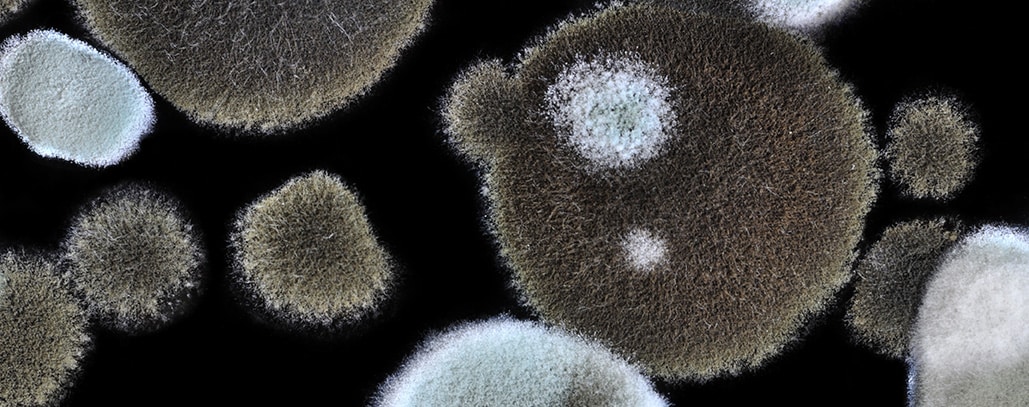
Understanding Mold and Apartment Mold Laws

Our Previous Clients
SUCCESSFUL JOBS
Happy Clients
Locations
Our Services
Environmental Services
Indoor Air Quality
Fire & Life Safety
Building Services
Industries We Worked With
A Reputation You Can Trust
With Over 30 Years of Experience, Alliance Environmental is one of the leading environmental, indoor air quality, fire life safety, biohazard, and heat contractors on the west coast.
Our Certifications
You Can Count On Us
Certified
With over 26 years of experience, Alliance Environmental has a team of tenured, certified experts in their specialized fields. Our services meet or exceed all OSHA and EPA guidelines and we leverage cutting-edge tools to recommend solutions and establish an order of operations and project management disciplines.
Quality
Alliance Environmental maintains an extensive quality control program with superior customer service to deliver best in class.
Timely
Alliance Environmental is prepared to respond with urgency and efficiency to minimize business and personal interruptions. We are committed to providing speedy consultation, cost estimates, notifications, and containment.
Bonded
Alliance Environmental carries $2,000,000 True Occurrence Insurance and can obtain specific job coverage up to $5,000,000.
Affordable
You’ll find our prices competitive, reasonable, and affordable.
Our Resources
What Is Asbestos Abatement?
Toward the end of the 19th century, builders began making widespread use of a material that had been found to have...
Are There Lead Paint Removal Requirements for Property Owners?
To mitigate this, California has enacted certain lead paint removal requirements to prompt landlords to handle any...
Understanding Mold and Apartment Mold Laws
Mold is a common indoor environmental hazard that can cause concern for everyone from renters and apartment landlords,...
Contact Us
Whether you need support with environmental services, indoor air quality (IAQ), fire & life safety compliance, or demolition projects, our team is here to help contact us today and we’ll connect you with the right specialist.